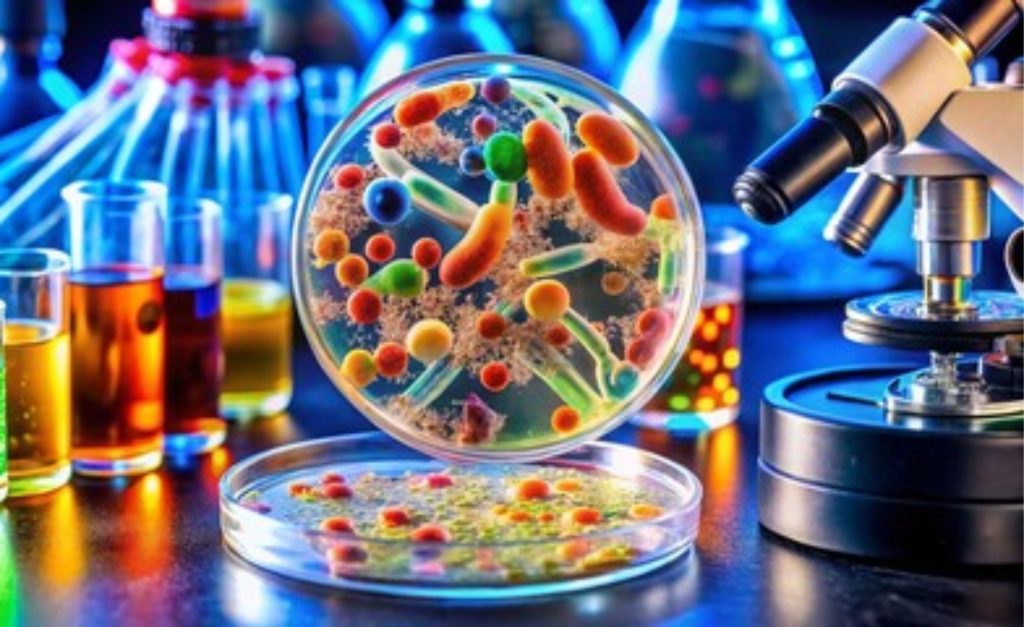
Brucelose. ⚠️ Doença silenciosa reforça a importância da inspeção no leite.

Brucelose é a palavra que ainda assombra a cadeia do leite em Goiás. A doença infecciosa, transmitida de animais para humanos, segue representando um risco à saúde pública — especialmente quando o consumo de leite cru e derivados sem inspeção continua presente nas feiras, mercados e pequenas produções artesanais.
A Agência Goiana de Defesa Agropecuária (Agrodefesa) e a Secretaria de Estado da Saúde de Goiás (SES-GO) reforçaram neste mês o alerta à população: apenas produtos com selo oficial de inspeção garantem segurança alimentar.
O perigo invisível do “leite fresco”
Nem todo leite “fresco” é sinônimo de pureza ou qualidade. Queijos e derivados sem registro sanitário podem se transformar em veículos de contaminação. Em humanos, a brucelose provoca sintomas como febre prolongada, dores nas articulações, fraqueza, suores noturnos e perda de apetite, facilmente confundidos com doenças comuns como gripe ou dengue.
O controle começa no campo
O combate à doença, segundo a Agrodefesa, exige uma ação coordenada que vai desde o produtor até o consumidor final. No campo, as equipes atuam com registro e monitoramento dos rebanhos, orientação técnica aos produtores e fiscalização da vacinação obrigatória de fêmeas bovinas e bubalinas entre três e oito meses de idade.
Para Denise Toledo, gerente de Sanidade Animal da Agrodefesa, a vacinação é a principal barreira contra a doença.
“Animais positivos precisam ser eliminados, protegendo a saúde do rebanho e o investimento do produtor, além de garantir a segurança alimentar da população”, afirmou.
O controle rigoroso é essencial, porque o impacto econômico de um foco de brucelose pode ser devastador — tanto para o produtor individual quanto para toda uma região produtora.
Inspeção rigorosa: do laticínio ao queijo artesanal
Goiás tem tradição no leite artesanal, e é justamente aí que o risco aumenta. Para garantir a qualidade dos produtos, a Agrodefesa mantém fiscalização industrial e sanitária permanente, incluindo:
-
Certificação de estabelecimentos com selo de inspeção;
-
Verificação de boas práticas de fabricação;
-
Controle de rastreabilidade em produtos artesanais feitos com leite cru;
-
Garantia de matéria-prima proveniente de animais sadios.
O gerente de Inspeção da Agrodefesa, Paulo Viana, foi enfático:
“Produtos sem registro podem esconder perigos invisíveis. O consumidor deve sempre optar por alimentos fiscalizados e com selo oficial.”
Educação e prevenção
Além das ações no campo, o trabalho de prevenção depende de informação e conscientização.
De acordo com Fabrício Augusto de Sousa, coordenador de Zoonoses da SES-GO, a melhor forma de se proteger é simples:
-
Beber apenas leite pasteurizado;
-
Consumir derivados com selo de inspeção;
-
Usar luvas e máscaras ao lidar com animais;
-
Procurar atendimento médico diante de sintomas suspeitos.
Essas medidas, segundo ele, precisam chegar não só aos produtores, mas também aos consumidores urbanos, que frequentemente compram queijos e leites “frescos” em feiras e pontos de venda informais.
Casos em crescimento preocupam
De acordo com dados oficiais da SES-GO, em 2024 foram notificados 34 casos de brucelose em humanos no estado. Entre janeiro e setembro de 2025, já são 24 casos confirmados. Especialistas acreditam que o número real possa ser ainda maior, devido à subnotificação e confusão com outras doenças.
A Agrodefesa reforça que, embora a maioria dos casos ocorra em áreas rurais, o risco também se estende às cidades, onde produtos sem registro circulam livremente.
Entre tradição e modernidade: o futuro do leite goiano
Goiás é referência nacional na produção de leite e abriga milhares de famílias que dependem da atividade. O desafio, no entanto, é equilibrar a tradição dos produtos artesanais com as exigências sanitárias da modernidade.
A brucelose não é apenas um problema de saúde — é também uma ameaça à imagem e à sustentabilidade da cadeia láctea brasileira. A erradicação exige compromisso coletivo: produtores responsáveis, indústrias fiscalizadas e consumidores conscientes.
No coração do Brasil, a mensagem é clara: o leite seguro começa no campo, mas termina na escolha de cada consumidor.
*Escrito para o eDairyNews, com informações de Radar Digital